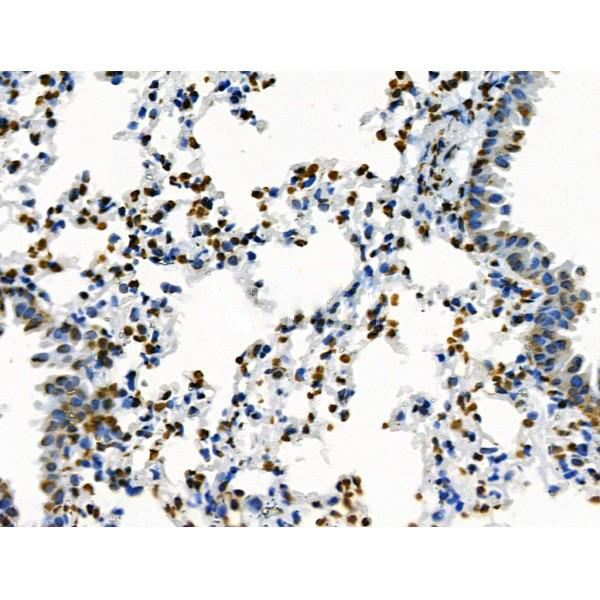

Core component of nucleosome. Nucleosomes wrap and compact DNA into chromatin, limiting DNA accessibility to the cellular machineries which require DNA as a template. Histones thereby play a central role in transcription regulation, DNA repair, DNA replication and chromosomal stability. DNA accessibility is regulated via a complex set of post-translational modifications of histones, also called histone code, and nucleosome remodeling.
Description
Rabbit polyclonal antibody to Acetyl-histone H4 (Lys16)
Applications
WB, IF, ICC, IHC
Immunogen
Acetyl-histone H4 (Lys16) Antibody detects endogenous levels of histone H4 only when acetylated at Lys16.
Reactivity
Human, Mouse, Rat.
Molecular weight
11kD(Calculated).
Host species
Rabbit
Ig class
Immunogen-specific rabbit IgG
Purification
Antigen affinity purification
Full name
Acetyl-histone H4 (Lys16)
Synonyms
dJ160A22.1; dJ160A22.2; dJ221C16.1; dJ221C16.9; FO108; H4; H4.k; H4/a; H4/b; H4/c; H4/d; H4/e; H4/g; H4/h; H4/I; H4/j; H4/k; H4/m; H4/n; H4/p; H4_HUMAN; H4F2; H4F2iii; H4F2iv; H4FA; H4FB; H4FC; H4FD; H4FE; H4FG; H4FH; H4FI; H4FJ; H4FK; H4FM; H4FN; H4M; HIST1H4A; HIST1H4B; HIST1H4C; HIST1H4D; HIST1H4E; HIST1H4F; HIST1H4H; HIST1H4I; HIST1H4J; HIST1H4K; HIST1H4L; HIST2H4; HIST2H4A; Hist4h4; Histone 1 H4a; Histone 1 H4b; Histone 1 H4c; Histone 1 H4d; Histone 1 H4e; Histone 1 H4f; Histone 1 H4h; Histone 1 H4i; Histone 1 H4j; Histone 1 H4k; Histone 1 H4l; Histone 2 H4a; histone 4 H4; Histone H4; MGC24116;
Storage
Rabbit IgG in phosphate buffered saline , pH 7.4, 150mM NaCl, 0.02% sodium azide and 50% glycerol. Store at -20 °C. Stable for 12 months from date of receipt.
Swissprot
P62805




 产品订购:
产品订购:
 渠道电话:
渠道电话: